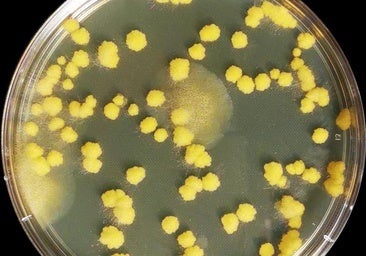

Así se puede reducir el riesgo de sufrir diabetes según un estudio de la UMH
La dieta mediterránea hipocalórica combinada con actividad física son claves para conseguirlo
La dieta mediterránea hipocalórica combinada con actividad física reduce el riesgo de diabetes tipo 2. Es la principal conclusión de un estudio en el que han participado investigadores de la Universidad Miguel Hernández de Elche, y que ha sido publicado en la revista Annals of Internal Medicine.
La diabetes tipo 2, una patología crónica ligada al sobrepeso y la obesidad, ha aumentado de forma notable en los últimos años y afecta seriamente a la salud y la calidad de vida.
El estudio forma parte de PREDIMED-Plus, la continuación del proyecto PREDIMED, que ya había demostrado que la dieta mediterránea suplementada con aceite de oliva virgen extra o frutos secos reducía en un 30% la incidencia de diabetes, aunque con un efecto limitado sobre el peso corporal. En el estudio se han seguido durante seis años a 4.746 personas de entre 55 y 75 años con sobrepeso u obesidad y síndrome metabólico, pero sin enfermedad cardiovascular ni diabetes al inicio.
Noticia relacionada
Hallazgo pionero de la UMH sobre la resistencia de los hongos a los fármacos
Por parte de la UMH, los firmantes del trabajo son el investigador principal de la Unidad de Epidemiología de la Nutrición (EPINUT-UMH) Jesús Vioque López, junto a las investigadoras postdoctorales Laura Torres Collado y Sandra González Palacios, con el reconocimiento del resto del equipo y los médicos de atención primaria que han sido claves en el reclutamiento y seguimiento de los pacientes.
Participantes elegidos al azar
Los participantes fueron asignados al azar a dos programas: uno basado en la dieta mediterránea, pero sin restricción calórica ni fomento del ejercicio, y otro de intervención intensiva, que combinaba una dieta mediterránea hipocalórica con una reducción de 600 kilocalorías diarias junto a un programa de mayor actividad física y apoyo conductual para perder peso.
Los participantes asignados a la intervención intensiva mostraron una mayor adhesión a la dieta mediterránea, aumentaron su actividad física, perdieron más peso y necesitaron menos medicación para controlar la glucosa tras un diagnóstico de diabetes. Además, el riesgo de desarrollar la enfermedad fue del 9,5% (280 casos) frente al 12% (349 casos) del grupo con dieta mediterránea sin restricción, lo que supone una reducción relativa del 31%.
Según el equipo investigador, los componentes de la dieta mediterránea «actúan de forma sinérgica en procesos clave de la diabetes tipo 2, como la resistencia a la insulina, la inflamación o el estrés oxidativo. Estos efectos se potencian con la actividad física y la pérdida de peso. Además, al tratarse de una dieta sabrosa, sostenible y culturalmente aceptada, constituye una estrategia ideal a largo plazo para prevenir enfermedades cardiometabólicas».